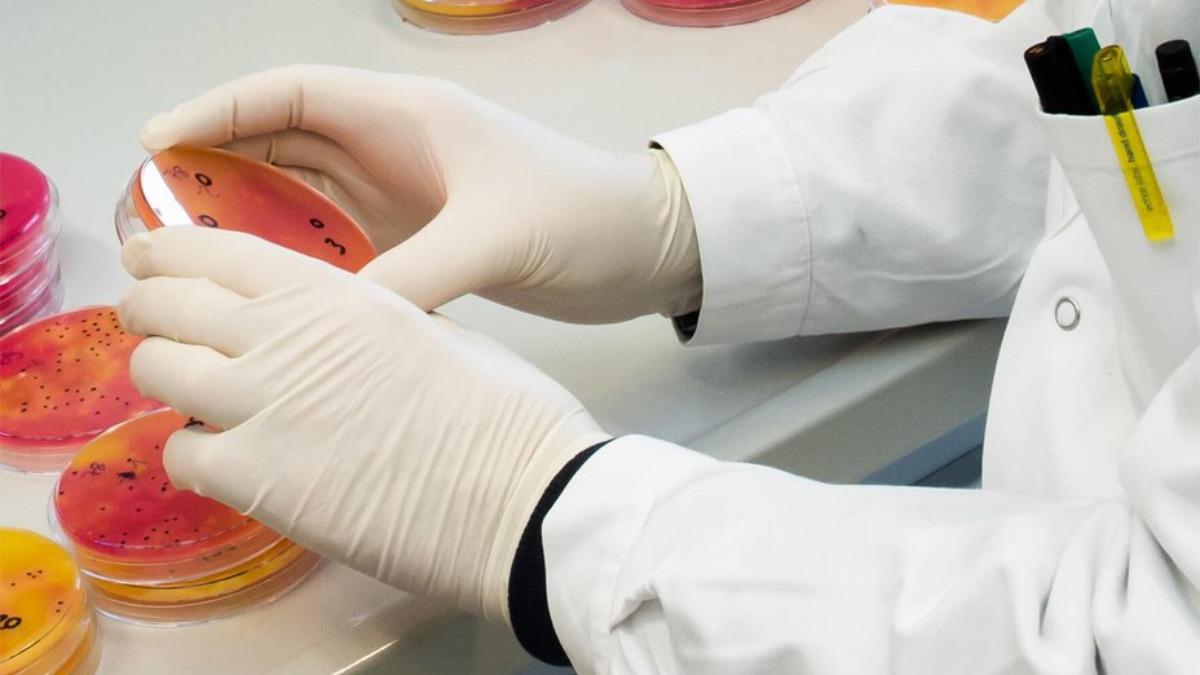
La investigación se centra en el llamado resistoma, el conjunto de genes que permiten a las bacterias resistir los efectos de los antibióticos.

Microbiología / Genética
Más del 70 % de los genes resistentes a los antibióticos están en nuestro sistema alimentario
Se proyecta que para 2050 las muertes por infecciones resistentes a los antibióticos podrían alcanzar los 10 millones al año en todo el planeta
La investigación se centra en el llamado resistoma, el conjunto de genes que permiten a las bacterias resistir los efectos de los antibióticos. / Crédito: Michael Bernkopf/Vetmeduni.
Redacción T21
Los sistemas de producción de alimentos pueden actuar como rutas de transmisión de bacterias resistentes a los antibióticos y sus genes: la mayoría se encuentran en productos cárnicos y lácteos, y donde menos hay es en la producción pesquera. Se pueden transferir al microbioma intestinal y están fuertemente influenciados por los entornos de procesamiento y producción.
Un consorcio europeo liderado por la Universidad Veterinaria de Viena, en Austria, y la Universidad de León, en España, acaba de publicar un nuevo estudio en la revista Nature Microbiology que analiza el “resistoma” alimentario en 1.780 muestras procedentes de materias primas, productos finales y superficies de 113 industrias en el ámbito europeo.
Un problema de salud global
Los genes de resistencia a los antibióticos son segmentos de ADN que permiten a las bacterias sobrevivir a los tratamientos con antibióticos, ya sea modificando el antibiótico, volviéndolo inactivo o evitando que llegue a su objetivo dentro de la bacteria. Este sistema, denominado resistoma, permite que los genes se puedan transmitir entre bacterias, simplificando la propagación de la resistencia.
La resistencia a los antibióticos es un grave problema de salud pública global, que genera millones de muertes cada año: se estima que las muertes por esta causa podrían alcanzar los 10 millones anuales para 2050, superando incluso a las muertes por cáncer y accidentes de tránsito. En ese escenario, el circuito alimentario cumple un papel vital, que ha sido escasamente explorado.
Aunque ya se sabía que la cadena alimentaria puede actuar como vía de transmisión de bacterias resistentes a los antibióticos, hasta la fecha ningún estudio había analizado en profundidad esta relación. Según una nota de prensa, los investigadores aplicaron secuenciación metagenómica para mapear casi 2.000 muestras de leche, carne, pescado, queso, vegetales y entornos industriales.
El hallazgo principal revela que más del 70 % de los genes de resistencia antimicrobiana circulan a lo largo de toda la cadena de producción alimentaria europea. Destacan principalmente los productos cárnicos y lácteos como transmisores, en tanto que la producción pesquera se ve menos afectada. Los expertos sostienen que estos genes pueden incidir en el microbioma intestinal.
Superficies de contacto y entornos de producción como actores fundamentales
Las clases de antibióticos con mayor representación en el resistoma fueron tetraciclinas, β-lactámicos, aminoglucósidos y macrólidos, compuestos fundamentales tanto en medicina humana como veterinaria. Entre los principales portadores de estos genes se identificaron bacterias como Escherichia coli, Staphylococcus aureus y Klebsiella pneumoniae, largamente estudiadas por su influencia en la alimentación.
El análisis por tipo de muestra mostró que las superficies de contacto con alimentos (mesas, cintas transportadoras) y las no alimentarias presentaron la mayor carga y diversidad de genes de resistencia, incluso superando a los productos terminados y las materias primas. Esto sugiere que las plantas de producción actúan como reservorios activos y puntos críticos de diseminación de resistencia antimicrobiana.
Referencia
The food-associated resistome is shaped by processing and production environments. Narciso M. Quijada et al. Nature Microbiology (2025). DOI:https://doi.org/10.1038/s41564-025-02059-8
Un hallazgo alarmante es la asociación de aproximadamente el 40 % de los genes de resistencia con plásmidos, elementos genéticos móviles capaces de transferir estos determinantes entre distintas bacterias. Esta movilidad eleva significativamente el riesgo de diseminación horizontal de resistencia en el ambiente industrial y, posteriormente, en el consumidor final.
En definitiva, estos resultados ofrecen información clave para diseñar estrategias de uso más racional de antibióticos y biocidas en la producción. La adopción de medidas de vigilancia metagenómica, combinada con mejoras en protocolos de limpieza y control de procesos, podría contener la propagación de estos genes de resistencia antes de su llegada al consumidor o a entornos clínicos.
Vía: Levante - EMV
- “No hay nadie mejor”: el aviso de Luis Enrique que sacude la Champions
- El presupuesto del Barça para fichar en el próximo mercado: Bastoni y Julián, los objetivos
- Kounde no duda y escoge a su jugador favorito del Barça: 'Es absolutamente brillante
- La estrategia de Bastoni con Cubarsí para acercarse al Barça
- Barça - Efes: resumen, resultado y estadísticas del partido de la Euroliga
- ¡Inaudito! El Comité de Competición perdona a Valverde y solo le cae un partido de sanción
- Plan en el Barça para la posición de central: confianza para Araujo y Christensen, en el aire
- Noelia, de 25 años, anuncia que recibirá la eutanasia este jueves: 'Quiero irme ya en paz y dejar de sufrir